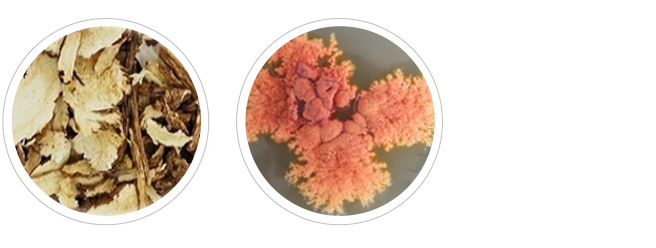

이앤사이언스 핵심 기술력 – 100% NATURAL
최근 합성유해성분의 유해성에 대한 논란이 계속되고 있으며, 이러한 논란의 영역은 확대될 것입니다.
인체에 접촉하는 제품들을 천연화 기술을 통해 제품화하고, 이를 통해 보다 안전하고
기능적으로 우수한 제품을 개발합니다.


통일된 기준으로 소비자들에게 신뢰성을 주기 위해 유럽 5개국이 연합하여 통합 마련한 천연 인증 기준이 COSMOS 인증!
이 인증 기준도 5% 이내에서 합성을 허용하기 때문에, 단순히 인증을 받는 것이 아닌, 100% NATURAL 인증 완료!


이앤사이언스 핵심 기술력 - 생명공학적 발효
천연 소재들은 인체의 안정성이 높은 대신 기능이 약함 그리고 인체 흡수력이 떨어집니다.
발효는 미생물의 활동을 이용한 것으로, 발효를 하면 미생물을 비롯하여, 발효과정에서 생성되는
각종 효소들로 인해 기능성이 증대되거나 새로운 기능성이 생기며
미생물이 대사하는 과정에서 만들어진 물질이기 때문에 저분자화 되어 있어 흡수가 용이합니다.


발효에는 우수한 물질을 만들어내는 미생물을 이용하는 것이 중요합니다.
유기산을 비롯한 다양한 생리활성 물질을 생산하는 유산균 외 다양한 미생물 국제특허균주기탁!


이앤 사이언스 공인인증


이앤사이언스가 추구하는 기본적인 기능
항산화
인체는 노화가 진행되면서 세포의 활성이 떨어지고, 각 장기의 기능이 저하가 되며 체내외에서 활성산소의 접촉이 많을수록 노화는
촉진됩니다.
대사를 통해서도 체내에 많은 활성산소가 생성되지만, 최근에는 공해나 합성물질의 접촉이 많아지면서 활성산소에 더 많이
노출됩니다. 또한
활성산소를 억제해야(항산화) 노화 진행을 최대한 지연시킬 수 있으므로, 근본적인 건강 유지를 위해서는 항산화가
중요합니다.
면역
면역은 인체 내 침입한 다양한 유해 환경(세균, 바이러스, 유해성분 등)에 대응하는 방어체계입니다.
면역이 정상적으로 작동하지 못하면 유해환경에 제대로 대응을 할 수 없게 되고, 정상 세포들이 손상을 입게 되면서 각 장기의 기능에 영향을
줍니다. 또한
면역력이 좋아져야 인체 내 침입한 유해 환경으로부터 제대로 보호가 되기 때문에 건강 유지를 위해서는 면역이 중요합니다.
더이앤(THE EN) 제품에 적용된
기술1 - 참당귀발효추출물
▶ 참당귀는 한방 소재로 사용되며 데커신 등 다양한 면역물질 함유
▶ 홍국균은 모나콜린K라는 붉은색 활성물질 외에도 항산화물질 등 다양한 생리활성 물질을 만드는 미생물

(※ 참당귀를 홍국균으로 7~10일 발효)



더이앤(THE EN) 제품에 적용된
기술2 - 복합버섯추출물
▶ 건버섯은 β-glucan 등 다양한 면역물질과 천연 보습성분인 다당체 성분을 다량 함유
▶ 목이버섯 / 동충하초균사 / 영지버섯 / 차가버섯 / 진흙버섯


※ 상기 내용은 원료적 특성에 한정한 내용입니다.









